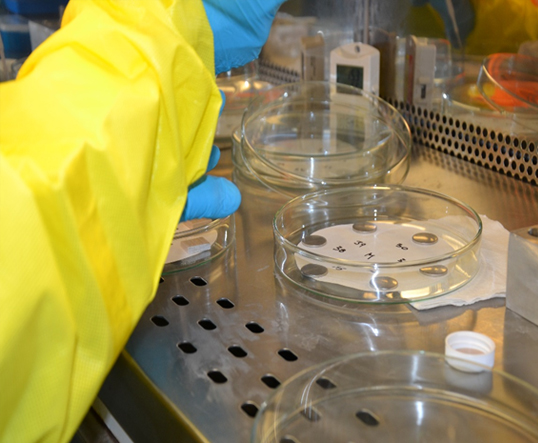

SIBCRA Pro intelligent solutions span all phases of the R&D project lifecycle, starting with a drawing board. We offer complete customization to match your exact needs. Our testing and evaluation services follow major world standards.
Consultancy and Test Services
SIBCRA Pro intelligent solutions span all phases of the R&D project lifecycle, starting with a drawing board. We offer complete customization to match your exact needs. Our testing and evaluation services follow major world standards.
Know-how to consult and assist in finding the most practical and economical solution for any testing need.
Chemical Warfare Agents (CWAs) are highly toxic chemicals, requiring special safety and regulatory measures. They are not widely available and their application in testing may not be achievable for you.
Help in choosing right chemical simulant for CWAs for the testing. A chemical simulant mimics relevant properties of respective CWA without its toxicity. We run correlation tests using your test method and materials to compare proposed simulant candidates with authentic chemical warfare agents!
Analytical methods applied in CBRN testing must be capable of detecting target compounds at concentrations (doses) comparable to those inducing physiological responses. Margin of uncertainty in result might bear potential for causing injury or death in real world.
Know-how to consult and assist in finding the most appropriate and accurate analytical setup for a test: data acquisition, analysis, interpretation and reporting.
Off-Site testing services with authentic CBRNE agents
- Test design
- Indoor / Outdoor live agent tests in facilities located in Europe with or without your presence. Our outdoor facilities allow for testing of long range stand off detectors and drone borne CBRNE reconnaissance systems.
- Test results provision (photos, videos, raw analytical data files)
- Data analysis, conclusions and recommendations
- Test follow-up
Use of chemicals such are Chemical Warfare Agents (CWA’s), Toxic Industrial Chemicals (TIC’s), and even some simulants requires highly trained operators.
Consulting and user training on laboratory safety component: risk assessment, protection, handling of hazardous materials, decontamination, medical emergency measures, waste management.